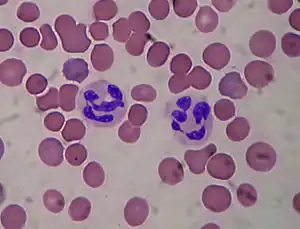

Système immunitaire inné

Le système immunitaire inné comprend les cellules et les mécanismes permettant la défense immédiate de l'organisme contre les agents infectieux de façon immédiate[1] car elle ne nécessite pas de division cellulaire. Il s'oppose en cela au système immunitaire adaptatif, qui confère une protection plus tardive mais plus durable[2], et qui nécessite une division cellulaire (lymphocyte B et T).
Bien que cette défense ne soit pas spécifique d'une espèce particulière d'agent pathogène, elle peut reconnaître des types de pathogènes, comme par exemple les bactéries Gram négatif qui sont reconnues par les récepteurs appelés pattern recognition receptor (PRR) ou en français récepteur de reconnaissance de motifs moléculaires[3].
Alors que le système immunitaire adaptatif existe uniquement chez les gnathostomes, le système immunitaire inné existe dans tous les organismes du règne végétal et animal.
Les principales fonctions du système immunitaire inné des chordés sont :
- La constitution d'une barrière physique et chimique contre les agents infectieux ;
- L'identification et l'élimination de corps étrangers présents dans l'organisme, les tissus, le sang et la lymphe, par les globules blancs ;
- La détection des agents infectieux et le recrutement de cellules immunitaires sur le site de l'infection ;
- L'activation de la cascade du complément permettant l'activation des cellules et l'élimination de cellules mortes ou de complexes immuns ;
Protection passive
Barrière anatomique

L'épithélium est une barrière physique constituant l'une des premières défenses contre les agents infectieux[5]. C'est une barrière mécanique, du fait de sa faible perméabilité. La desquamation de l'épiderme permet également d'éliminer des bactéries ou autres agents infectieux ayant adhéré à la surface de l'épithélium.
Les muqueuses ont un épithélium non kératinisé, par nature plus perméable, et sont donc plus sensibles aux différentes attaques infectieuses. Elles ont développé un moyen de défense supplémentaire : le mucus. Dans le tube digestif et les voies respiratoires, le mouvement opéré par le péristaltisme ou les cils contribuent à l'élimination des agents infectieux.
La flore commensale, qui est un ensemble de bactéries se situant sur la peau et les muqueuses, joue un rôle important de barrière. Elle prévient la colonisation par des bactéries pathogènes, en agissant notamment par compétition pour les nutriments.
Les larmes et la salive contribuent également à prévenir l'infection des yeux et de la bouche, respectivement.
| Barrière anatomique | Mécanismes correspondants |
|---|---|
| Peau | Transpiration, desquamation, acides organiques |
| Tube digestif | Péristaltisme, mucus, acide gastrique, acide biliaire, enzymes digestives, thiocyanate, défensines, flore intestinale |
| Voies respiratoires et poumons | Mucus, surfactant pulmonaire, défensines |
| Rhinopharynx | Mucus, salive, lysozyme |
| Yeux | Larmes |
| Paroi vaginale | Flore de Doderlein |
Barrières chimiques
La barrière chimique de la peau est constituée de nombreux lipides et acides sécrétés. la couche lipidique sécrétée par les corps lamellaires est importante pour maintenir une matrice occlusive entre les cellules et entre les couches de la couche cornée[6],[7]. La teneur en lipides spécifiques à un site influence également la composition microbienne de divers sites corporels cutanés[8]. En fait, la composition microbienne est relativement homogène entre plusieurs sites sébacés mais varie considérablement entre les sites cutanés avec glandes sébacées et les sites cutanés sans glandes sébacées[8]. Les microbes pathogènes sont également directement inhibés par certains lipides ou acides gras libres. Par exemple, l'acide sapienique peut inhiber efficacement Staphylococcus aureus pathogène, mais n'a pas une activité suffisante contre Staphylococcus epidermidis[9]. Dans l’ensemble, la barrière chimique formée par les lipides épidermiques et les acides gras est importante pour moduler la survie microbienne à la surface de la peau.
De plus, la couche cornée de l’épiderme maintient un pH acide dans des conditions homéostatiques. Le terme « manteau acide » a été utilisé pour décrire l’état acide de la couche cornée[10]. Ce pH acide est important pour la fonction de barrière cutanée et la défense microbienne en fournissant un environnement hostile à certains micro-organismes[6],[11]. En outre, il existe un certain nombre d’enzymes dépendantes du pH qui sont essentielles à la synthèse, à la production et au maintien de la composition lipidique de la peau. Les lipides, tels que les triglycérides et le cholestérol, sont hydrolysés par les bactéries et les levures résidant dans la peau en acides gras libres. Les acides gras libres maintiennent un pH bas qui inhibe la croissance d'espèces pathogènes telles que Staphylococcus aureus (S. aureus), tout en permettant la persistance de bactéries commensales telles que Staphylococcus à coagulase négative et Corynebacterium[12],[13].
Microbiote cutanée
La peau et l’intestin abritent une immense diversité et un grand nombre de microbiotes. Tant dans la peau que dans l’intestin, le microbiote commensal est important pour maintenir l’homéostasie épithéliale et la santé globale des tissus[14],[4]. Des sites cutanés distincts contiennent une distribution unique de bactéries, en partie régie par la composition lipidique d'un site cutané[11]. Par exemple, les zones riches en glandes sébacées, telles que la glabelle et le dos, sont colonisées principalement par des espèces de Cutibacterium (anciennement connues sous le nom de Propionibacterium), qui sont étroitement associées à l'acné vulgaire[11]. Les sites humides, tels que les espaces axillaires et interdigitaux, sont largement colonisés par les espèces de Corynebacteria et de Staphylococci[11]. Outre les bactéries, qui constituent le règne d'organismes le plus abondant présent sur la peau, de nombreux champignons et virus habitent la peau[11]. Contrairement aux bactéries, présentes dans presque tous les sites corporels et dont la composition est régie par des conditions physiologiques, la distribution fongique varie en fonction de sites corporels distincts plutôt que de conditions physiologiques[15]. Le tronc et les bras ont une composition fongique relativement homogène et sont principalement colonisés par des espèces de Malassezia, tandis que le pied abrite une diversité fongique beaucoup plus grande[15]. La composition virale, principalement les Polyomaviridae et les Papillomaviridae, présente la plus grande diversité entre les individus, plutôt que selon la zone corporelle ou la composition[16].
Au niveau de la peau, la présence de bactéries commensales est cruciale pour le maintien d'un environnement cutané sain. Au cours du développement, la tolérance immunitaire cutanée commence à se développer dans la période postnatale, lorsque les cellules T reg commencent à exprimer le facteur de transcription FOXP3 spécifique de l'agent pathogène, coïncidant avec la colonisation commensale[17]. Plus tard dans le développement, la présence continue de bactéries commensales cutanées module la production de nombreuses cytokines et peptides anti-microbiens qui aident à protéger la peau contre les agents pathogènes. Par exemple, des bactéries commensales telles que S. epidermidis peuvent induire la production de diverses cytokines par les cellules T IL-17+CD8+[17]. S. epidermidis peut également produire des ligands qui suppriment une activation immunitaire inappropriée en inhibant la production du facteur de nécrose tumorale α et de l'IL-6[18].
Le système immunitaire inné constitue une première ligne de défense contre les agents pathogènes en cas de rupture de la barrière. Des preuves récentes ont mis en lumière le rôle des microbes commensaux dans le renforcement de la défense immunitaire innée contre les agents pathogènes[19]. Dans la peau, les motifs moléculaires associés aux pathogènes sont présents sur les cellules immunitaires et les kératinocytes. La stimulation des récepteurs de type Toll peut induire une action antimicrobienne directe en stimulant les macrophages pour qu'ils subissent une phagocytose et peut également induire des cytokines qui interviennent dans la différenciation des monocytes en macrophages et en cellules dendritiques[20],[21]. Les microbes commensaux sécrètent des molécules qui peuvent agir directement comme ligands du TLR ; S. epidermidis sécrète plusieurs petites molécules qui agissent comme des agonistes du TLR2 et de l'EGFR, stimulant la production de peptides antimicrobien ayant une activité contre les streptocoques du groupe A et S. aureus[22],[23],[24].
Peptides antimicrobiens

Les peptides anti-microbiens (PAM) sont des oligopeptides comprenant de 6 à 100 acides aminés. Ces peptides sont de puissants antibiotiques à large spectre. Ils constituent la première ligne de défense chimique.
Il a été démontré que les peptides antimicrobiens tuent les bactéries à Gram négatif et à Gram positif, les virus enveloppés, les champignons et même les cellules transformées ou cancéreuses[25],[26].
La plupart des PAMs sont produits en permanence par les cellules, mais quelques-uns sont produits lorsqu'il y a un agresseur spécifique comme le P9A et le P9B produits après l'injection d’Enterobacter cloaca chez un papillon[27] ou de défensine produite après l'infection de Pseudomonas aeruginosa chez la souris[28].
La sélectivité est une caractéristique très importante des peptides antimicrobiens, et peut garantir leur fonction d'antibiotique dans les systèmes de défense de l'hôte. Des différences fondamentales existent entre les cellules procaryotes et eucaryotes, pouvant représenter des cibles pour les peptides antimicrobiens. Dans la compétition des cellules bactériennes et des cellules hôtes avec les peptides antimicrobiens, les peptides antimicrobiens vont interagir préférentiellement avec la cellule bactérienne, ce qui leur permet de tuer des micro-organismes sans être significativement toxiques pour les cellules de mammifère[29].
Les peptides antimicrobiens possédant une charge nette positive sont attirés et incorporés dans les membranes bactériennes chargées négativement. Une fois à l'intérieur de la membrane, ils sont supposés causer des perturbations variées. Bien que les spécificités de chaque mécanisme diffèrent, toutes proposent une rupture de la membrane induite par un peptide, permettant ainsi une fuite cytoplasmique, qui conduit finalement à la mort.
Signatures des pathogènes
Récepteurs
Une cellule de l'immunité innée reconnaît les agents pathogènes quand les récepteurs de ses cellules se fixent sur des molécules ou des portions de molécules caractéristiques qui ne sont pas exprimées par les cellules de l'organisme dans lequel elle est implantée, sont donc identifiés comme non-soi. Certaines molécules libérées par les cellules endommagées appelées "Damage Associated Molecular Patterns" (DAMP) sont également reconnues par l'immunité innée, qui est ensuite stimulée pour éliminer ces cellules.
Les récepteurs de l'immunité innée sont des protéines que l'on peut trouver à la fois sur la membrane plasmique de certaines cellules immunitaires et au sein de leur cytoplasme ou sur la membrane des endosomes, mais il peut également s'agir de protéines dissoutes dans le sang ou dans les fluides extracellulaires. Leur tâche est de se lier à des structures moléculaires spécifiques présentes sur un microbe et par la suite d'activer une transduction de signal intracellulaire qui déclenche une réponse effectrice qui peut provenir de la cellule elle-même ou d'autres cellules (phagocytes et lymphocytes NK) recrutées par des médiateurs chimiques tels que cytokines.
Les récepteurs sont sensibles à trois catégories de signaux moléculaires :
- Les cellules effectrices du système immunitaire inné reconnaissent les agents pathogènes extérieurs par des récepteurs[3] appelés pattern recognition receptors (PRR) ou, en français, récepteurs de reconnaissance de motifs moléculaires, appelés encore récepteurs de pattern.
- Ces cellules effectrices peuvent reconnaître les dommages causés dans les cellules par les agents pathogènes : ce sont les signaux de danger.
- Le troisième mécanisme est le mécanisme de reconnaissance du soi et du non soi.
La gamme de molécules reconnues par l'immunité innée, appelées « Pathogen Associated Molecular Patterns » (PAMP), est cependant limitée, réduite à environ un millier de structures différentes, car les récepteurs de reconnaissance de formes (« Pattern Recognition Receptors », PRR) ont beaucoup moins de variabilité que ceux de l'immunité adaptative, qui peut reconnaître plusieurs milliards de molécules différentes. Les récepteurs PRR sont codés dans la lignée germinale et sur les cellules de la même lignée, et tous les récepteurs sont identiques.
Les principales classes de PRR associées aux cellules identifiées sont les récepteurs Toll-like (TLR), les lectines de type C, les récepteurs peptidiques formylés Met-Leu-Phe, les récepteurs scavenger, les NLR et les protéines de la famille CARD.
Système de reconnaissance des pathogènes (PRR)

La reconnaissance d'un pathogène par le système immunitaire inné repose sur deux outils : le motif moléculaire associé aux pathogène et les récepteurs de reconnaissance de motifs moléculaires.
L'efficacité de ce type de réponse immunitaire réside dans le fait qu'elle affecte presque toujours des structures essentielles à la survie du pathogène, par exemple le lipopolysaccharide de la paroi cellulaire bactérienne, pour lequel le non-soi n'est guère reconnu. Les motifs moléculaires sont des structures moléculaires associées aux pathogènes et qui n'existent pas chez les mammifères. Ces structures moléculaires sont indispensables aux pathogènes et sont donc peu susceptibles de mutation. Ces structures ne sont pas spécifiques d'une espèce mais d'une famille de microbes ; ces motifs moléculaires sont portés par toutes les familles de microbes, qu'ils soient ou non pathogènes pour l'organisme. Au lieu d'utiliser le terme de motifs moléculaires associés aux pathogènes (PAMP), il faudrait utiliser le terme de motifs moléculaires associés aux microbes (MAMP).
Les procaryotes sont plus faciles à distinguer que les eucaryotes (comme les parasites) par les récepteurs de reconnaissance de motifs moléculaires, car un parasite est plus proche phylogénétiquement d'un être humain que d'une bactérie. L'infection parasitaire (paludisme, toxoplasmose) est donc plus difficile à combattre pour l'organisme que l'infection virale ou bactérienne. Cela explique aussi la difficulté de la mise au point de vaccin contre les parasites.
| Famille de microbes | Motifs moléculaires |
|---|---|
| Virus | ARN double brin, ADN avec motif cytosine-guanine non méthylé |
| Bactérie gram-positive | Acide téichoïque, Acide lipotéichoïque, lipoprotéine, peptidoglycane |
| Bactérie gram-négative | Lipopolysaccharide, lipoprotéine, peptidoglycane |
| Mycobactérie | |
| Champignon | Glucane, mannane, ... |
Les récepteurs de reconnaissance de motifs moléculaires sont codés par les cellules de la lignée germinale, et sont spécifiques d'un motif moléculaire. On peut citer les récepteurs de type Toll (TLR), les récepteurs de type Nod (NOD), les récepteurs hélicases (RLR), les récepteur cGAS...
Système de reconnaissance des cellules lésées
Les motifs moléculaires associés aux dégâts (DAMP, Damage Associated Molecular Pattern)[30] sont des biomolécules de l'hôte qui peuvent causer et perpétuer une réponse inflammatoire à la suite de dégâts cellulaires de nature non infectieuse.
Les DAMP varient considérablement en fonction du type de cellule (épithéliale ou mésenchymateuse) et du tissu lésé. Les protéines DAMP comprennent les protéines intracellulaires, telles que les protéines de choc thermique[31] ou HMGB1 [32] (groupe à forte mobilité box 1), et les protéines dérivées de la matrice extracellulaire générées à la suite de lésions tissulaires, telles que des fragments d'acide hyaluronique[33]. Des exemples de DAMP non protéiques comprennent l'ATP, l'acide urique[34],[35], le sulfate d'héparine[36] et l'ADN[37].
Les DAMP peuvent être des protéines nucléaires ou cytosoliques qui, lorsqu'elles sont libérées de la cellule ou exposées à sa surface, à la suite d'une lésion tissulaire, passent d'un environnement réducteur à un environnement oxydant, entraînant leur dénaturation[38]. Après la nécrose (une sorte de mort cellulaire), l'ADN des cellules tumorales est libéré, avec le potentiel d'être reconnu comme étant un DAMP[37].
L'idée que le système immunitaire puisse reconnaître les cellules lésées par un pathogène au lieu du pathogène lui-même n'est pas une théorie admise par tous les scientifiques: protéine de stress, protéine de choc thermique comme le HSP ou l'actine. L'actine est un composé intracellulaire, la présence d'actine extra-cellulaire est une indication de cellule lésée.
Cellules de veille
Les leucocytes, ou globules blancs, se distinguent des autres cellules de l'organisme en cela qu'elles ne sont pas associées à un organe ou un tissu en particulier. Les leucocytes peuvent se déplacer librement dans l'organisme et capturer des débris cellulaires, des corps étrangers, ou des micro-organismes invasifs.
Ces cellules initialement présentes dans la plupart des tissus, comme les macrophages, les cellules dendritiques, les histiocytes, les cellules de Kupffer ou les mastocytes, détectent la présence de signaux inflammatoires et de motifs moléculaires associés aux pathogènes. Elles possèdent à leur surface des récepteurs de reconnaissance de motifs moléculaires. Ces récepteurs reconnaissent des molécules, appelées motifs moléculaires associés aux pathogènes, qui sont exprimées par les organismes microbiens, mais distinctes des molécules de l'organisme.
Les phagocytes (macrophages, polynucléaires neutrophiles) agissent en identifiant les antigènes, puis en phagocytant et digérant les agents infectieux qui les portent[39].
Une fois l’agent pathogène en place, il sera phagocyté par un phagocyte, qui sera par ce fait à l’origine du signal danger, activant ainsi la réaction inflammatoire si ce signal st important.
Les cellules du système immunitaire inné
Polynucléaires neutrophiles
Les polynucléaires sont les premières cellules à intervenir dés l'activation d'un PPR. Leur temps de réaction est très rapide. Il se compte en minutes
Les neutrophiles sont les phagocytes les plus nombreux, constituant 50 % à 60 % de l'ensemble des leucocytes circulants, et sont parmi les premières cellules recrutées au site d'infection. La moelle osseuse d'un individu sain adulte produit environ 100 milliards de neutrophiles par jour, et environ 10 fois plus au cours d'une infection aigüe. Le passage des polynucléaires neutrophiles dans le sang est rapide et bref, car ils jouent leur rôle essentiellement dans les tissus, où ils sont le principal agent cellulaire anti-bactérien. La durée de vie du polynucléaire neutrophile est très courte , de 7 à 24 heures , et il est entièrement consommé par sa fonction[40].
Modes d'actions
Ils sont au nombre de quatre
- Les neutrophiles ont un rôle primordial de phagocytose lorsqu'ils rencontrent une cellule étrangère ou infectée. Là, des vacuoles contenues dans les neutrophiles fusionnent avec la vacuole de phagocytose : leur contenu (lysozyme et granulations sécrétoires) détruit la cellule cible par un mécanisme toxique. Les granules présents dans le cytoplasme des neutrophiles contiennent des substances toxiques, produites par les éosinophiles principalement (eosinophil cationic peptide ECP, eosinophil derived neurotoxin EDN, peroxydases).
- Les défenses antiparasitaires se fondent sur la « dégranulation », qui est la libération de substance toxique pour le pathogène à l'extérieur de la cellule.
- L'activation de l'explosion oxydative (oxidative burst) par les neutrophiles conduit à la production de radicaux libres de l'oxygène et la sécrétion de peroxyde d'hydrogène et d'hypochlorite. Les neutrophiles libèrent beaucoup de molécules lors d'un contact avec un agent (lactoferrine, protéases, lysozymes, BPI), permettant l'élimination des microorganismes extracellulaires comme les bactéries ou les champignons. Ce processus entraîne la mort du neutrophile, car elle épuise toutes ses réserves en glucose. Ce mécanisme est également un mécanisme de défense pour les pathogènes trop gros pour être phagocytés, ce qui contribue à faire de lui une cellule anti-infectieuse, absolument non spécifique ; il peut en effet combattre une très grande variété de menaces différentes, mais avec un risque de dommage sur les cellules saines.
- Formation de filets extra-cellulaires (neutrophil extracellulaur traps NET), la nétose. Lors de l'action des neutrophiles ceux-ci expulsent en direction des bactéries (surtout) une substance très visqueuse et très collante, leur ADN. Les bactéries sont ainsi engluées et elles ne peuvent plus bouger, leur destruction est plus facile.
Macrophages
Cette cellule contient de très nombreux récepteurs : récepteurs PAMP & DAMP dont les récepteurs éboueurs , récepteurs opsoniques (récepteurs du complément, d'immunoglobulines) des cytokines (inflammatoire et anti-inflammatoire) , des chimiokines , de la co-activation notamment les récepteurs C5a et RAGE P2X impliqués dans les réactions d'anaphylatoxine, des récepteurs d'adhésion et des récepteurs inhibants
Les macrophages se divisent en deux sous ensembles les M1 et Les M2. Les M1 ont une activité destructrice et les M2 ont une activité réparatrices. Les M2 débarrassent notamment le lieu de l'inflammation des polynucléaires nécrosés. Cette différenciation se fait par la façon dont l'arginine est métabolisé :
- La métabolisation de l'arginine par l'oxyde nitrique synthase aboutit à l'oxyde nitrique qui a un pouvoir de prolifération cellulaire : M1
- La métabolisation de l'arginine par l'arginase aboutit à l'ornithine qui a un pouvoir de prolifération cellulaire et de réparation cellulaire : M2
Système phagocytaire

Le mot « phagocytose » signifie littéralement « ingestion de cellule ». Les phagocytes sont des cellules pouvant engouffrer (phagocyter) diverses particules, en particulier des agents infectieux. Les cellules les plus impliquées dans la phagocytose sont les macrophages, les monocytes, les polynucléaires neutrophiles et les cellules dendritiques : ce sont des « phagocytes professionnels ». La phagocytose s'adresse à des particules de grande taille, supérieures à 0,5 micron.
La phagocytose s'effectue en plusieurs étapes.

- Dans la phase d'adhérence, le phagocyte reconnaît le pathogène, directement par ses récepteurs de reconnaissance de motifs moléculaires, ou de façon indirecte par une opsonine, molécule se fixant sur le pathogène et reconnue par le phagocyte. Cette phase active la phagocytose.
- Le phagocyte allonge des parties de sa membrane plasmique, entourant ainsi progressivement la particule jusqu'à ce que cette dernière soit à l'intérieur de la cellule.
- À l'intérieur de la cellule, la particule phagocytée se trouve dans un endosome, qui fusionne ensuite avec le lysosome pour former le phagosome[39]. Le lysosome contient des enzymes et des acides permettant de tuer et de digérer la particule.
La phagocytose a deux fonctions :
- Elle détruit le pathogène, le réduisant en peptides ;
- Si nécessaire, elle commence la présentation de l’antigène, sous forme de ces peptides, par la cellule dendritique au lymphocyte T CD4+. Cette présentation de l’antigène est la première étape de la réponse adaptative de l'organisme à l'infection.
Les phagocytes permettent également l'élimination des cellules mortes de l'hôte, que celles-ci aient connu une mort programmée (apoptose) ou une mort cellulaire à la suite d'une infection bactérienne ou virale[2]. La phagocytose constitue ainsi un phénomène important dans le processus de cicatrisation.
Le mode d'action des phagocytes dépend de la cellule considérée.
- Les granulocytes (mastocytes, polynucléaires neutrophiles, éosinophiles et basophiles) neutralisent les antigènes par la libération de produits toxiques après phagocytose. Ce sont des « nettoyeurs » qui tuent les pathogènes en les exposant à des corrosifs comme le peroxyde d'hydrogène (eau oxygénée) et l'hypochlorite (eau de Javel).
- Les cellules dendritiques se spécialisent plutôt sur le déclenchement d'alertes, organisant la réaction tissulaire éventuelle (inflammation) et la réaction systémique. La fonction principale de la cellule dendritique est l'initiation de la réponse adaptative, en se déplaçant du lieu de l'infection vers le ganglion lymphatique pour présenter l'antigène à la cellule T CD4+ auxiliaire.
Opsonisation
L'opsonisation est une phagocytose déclenchée par l'activation d'un des deux récepteurs d'opsonisation du macrophage:
- Récepteur du complément (CR1, CR2, CR3)
- Récepteur d'immunoglobuline (CD16, CD32, CD 64). Le récepteur se lie avec la portion Fc d'une immunoglobuline produits par les lymphocyte B du système immunitaire adaptatif
C'est un processus biochimique par lequel une molécule (alors qualifiée d'opsonine) recouvre la membrane d'une cellule cible (une bactérie ou une cellule du corps infectée par un agent pathogène) pour favoriser sa phagocytose par une cellule dotée de récepteurs pour les opsonines, ou sa prise en charge par les molécules du complément.
Le pathogène ayant été marqué par l'opsonine, « sa tête est mise à prix », et il devient une cible légitime, mort ou vivant, pour l'une ou l'autre des cellules tueuses, ou pour les molécules du complément.
Monocyte
Cellules NK
Les cellules tueuses naturelles (NK) expriment un certain nombre de récepteurs[41],[42]:
- Reconnaissance directe des produits microbiens par TRL2[43], TRL3, TRL7 , TLR8 [44], TLR9 [45].
- Détecter les cellules aberrantes/transformées [qui manquent de molécules constitutives d'antigène leucocytaire humain (HLA)-I par les récepteurs KIR[46].
- Expression des ligands pour activer les récepteurs naturels cytotoxiques[47] (NCR).
Cellules NKT
Cellules lymphoïdes innées
Les cellules lymphoïdes innées sont relativement rares dans les tissus lymphoïdes et dans la circulation mais résident dans les organes non lymphoïdes et particulièrement dans les surfaces muqueuses[48]. Ces cellules peuvent se développer en l’absence de gènes activant la recombinaison, Rag-1 et Rag-2, et n’expriment donc pas les récepteurs antigéniques caractéristiques des lymphocytes T et B. Elles sont reconnues comme faisant partie de l’immunité innée mais peuvent posséder une certaine mémorisation[49]. Enfin, alors que d’autres cellules immunitaires innées s’appuient sur des récepteurs de reconnaissance de formes pour initier leur activation, le rôle des motifs tels que les récepteurs Toll-like (TLR) dans cette lignée cellulaire ne sont pas éclairci[50].
Police de conformité

Elles procèdent d'une logique différente : elles éliminent tout ce qui paraît être du « non-soi », c'est-à-dire les cellules qui présentent une déviance par rapport au complexe majeur d'histocompatibilité. Les NK reconnaissent les cellules à détruire par le complexe majeur d'histocompatibilité de type I (CHM ou MCH). Elles reconnaissent les cellules qui ne sont pas porteuses de l'antigène du soi.
Elles sont constitutivement cytotoxiques : ce sont des tueuses professionnelles. La cellule NK tendra à éliminer tout ce qui ne répond pas au standards du complexe majeur d'histocompatibilité. Elles participent à l'élimination des cellules cancéreuses, et des cellules infectées par un germe intracellulaire. Toute cellule qui présente une anomalie par rapport au complexe majeur d'histocompatibilité sera détruite.
Les récepteurs activateurs de la cellule NK sont en équilibre avec des récepteurs inhibiteurs de la cellule NK; et la non activation de la cellule NK résulte d'un équilibre entre des récepteurs inhibiteurs et des récepteurs activateurs présents dans une cellule NK. Ils ne produisent aucun effet tant qu'une cellule présente des signes positifs d’absence d'anomalies. Dans un état de non activation, la cellule NK reconnaît un ligand de son récepteur activateur sur une cellule saine et la cellule saine présente des peptides appartenant au soi sur son complexe majeur d'histocompatibilité de classe I au récepteur inhibiteur.
La reconnaissance des cellules à tuer par la cellule se fait principalement par activation des récepteurs des NK (NKR). L'activation est une rupture de l'équilibre naturel. Elle peut également être déclenchée par activation des récepteurs Fc a faible affinité, pour les immunoglobulines G. Une cellule infectée ou tumorale va exprimer des récepteurs cellulaires qui n’existent pas dans une cellule saine. La rupture de l'équilibre se fait de deux façons.
- En cas d'infection virale, de nombreux virus pour empêcher l'action des cellules immunitaires empêchent l'expression des complexes majeurs d'histocompatibilité de classe I[51], il n'y a donc pas de présentation de peptides viraux. Cette absence de complexe majeur d'histocompatibilité de classe débloque l'inhibition naturelle.
- En cas d'infection virale, bactérienne ou par des mycobactéries (tuberculose, listéria) ou cas de cellule cancéreuse, la cellule produit des protéines cellules de stress (MIC1, MIC2). Ces protéines vont stimuler puissamment les récepteurs activateurs de la cellule NK, aboutissant à la dégranulation de celle-ci.
- Par ailleurs, dans sa collaboration avec le système immunitaire adaptatif, la partie variable des immunoglobulines G se fixe sur ces récepteurs et déclenche l'action cytotoxique des cellules NK.
Les NK tuent de deux façons :
- par contact direct et libération du contenu de leur granules (granzymes, perforine) qui créent des pores dans la membrane cellulaire avec fuite de matériel cellulaire et la mort des cellules[52] ;
- par simulation des récepteurs de mort présent sur les cellules (death receptor Fas /Fas ligand du NK). Ce mécanisme ne serait pas le mécanisme principal[53],[54],[55].
Lymphocytes gamma delta
Les lymphocytes T gamma delta (γδ) sont des lymphocyte T dont les récepteurs sont composés de chaine gamma delta(γδ). Les lymphocytes T γδ humains comprennent trois populations cellulaires prédominantes (Vδ1, Vγ9Vδ2 et Vδ3) basées sur les différences dans la chaîne δ du récepteur (TCR)[56].
Lymphocytes Th17
Les cellules T helper (Th) 17 sont un sous-type de lymphocytes T CD4, spécialisés dans la réponse immunitaire contre les champignons et certaines bactéries extracellulaires[57],[58],[59]. L'interleukine (IL)-17A est la cytokine la plus représentative produite par les cellules Th17 [60], également produite par les lymphocytes T cytotoxiques et les lymphocytes innés, notamment γδ T, les cellules T tueuses naturelles et les lymphocytes du groupe 3 cellules lymphoïdes innées[61].
Cellules T régulatrices
Les cellules Treg sont essentielles au maintien de la tolérance périphérique, à la prévention des maladies auto-immunes et à la limitation des maladies inflammatoires chroniques en supprimant les réponses immunitaires de l'hôte et en induisant l'auto-tolérance[62]. Les cellules Treg CD4+ constituent un petit sous-ensemble (5 à 6 %) de la population globale de cellules T CD4+[63]. Foxp3 est un marqueur spécifique des cellules Treg CD4+ chez l'homme[64],[65],[66],[67].
Cellules mastocytaires
Les mastocytes proviennent de progéniteurs dérivés de la moelle osseuse qui, après un court passage dans le sang, migrent vers leur destination finale et se différencient en mastocytes matures[68]. Ils sont prédominants dans les tissus en contact étroit avec l’environnement extérieur, comme la peau ou au niveau des muqueuses, mais peuvent être retrouvés dans pratiquement tous les organes, augmentant souvent au cours d’un processus inflammatoire[69]. Les mastocytes protègent contre les infections parasitaires, les toxines telles que les venins de serpent, mais ils sont également responsables des allergies. Lorsqu'ils sont activés via les récepteurs IgE libèrent tout un ensemble de médiateurs inflammatoires stockés dans les granules cytoplasmiques, notamment l'histamine et diverses protéases[70]. Un récepteur couplé aux protéines G décrit récemment , le MRPRX2, interagit avec une grande variété de composés chimiques et de peptides chargés avec réactions dites pseudo-allergiques. Ce récepteur pourrait réagir avec les cellules périphériques du système nerveux[71],[72].
Cellules présentatrices d'antigène
Une cellule présentatrice d'antigène (ou CPA) est une cellule du système immunitaire qui présente des antigènes pour initier la réponse du système immunitaire adaptatif. Il peut s’agir de monocytes, de macrophages, de lymphocytes B ou de cellules dendritiques.
Après la phagocytose de l'élément étranger, celui-ci est décomposé en peptides élémentaires, qui sont placés à la surface de la CPA. Les peptides spécifiques à l'élément étranger seront reconnus comme antigènes. Ils sont présentés à des lymphocytes T.
Les lymphocytes T reçoivent l'information, et peuvent ensuite enclencher une réponse ciblée grâce à la reconnaissance des signatures spécifiques que constituent ces peptides. On passe alors d'une réponse immunitaire non spécifique (destruction d'un élément quelconque du non-soi) à une réponse immunitaire spécifique (destruction d’un élément précis du non-soi).
La réponse spécifique du lymphocyte T face à la reconnaissance de l'association CMH/antigène dépend du type de CMH et de la nature de l'antigène présenté. La présentation de l'antigène est notamment impliquée dans l'éducation des lymphocytes T lors du développement thymique, l'identification et la destruction des cellules infectées par les lymphocytes T cytotoxiques, et le recrutement des lymphocytes T auxiliaires dans la réponse immunitaire adaptative[73].
En principe, une cellule présentant un antigène à sa surface serait identifiée comme étrangère et détruite par le système immunitaire. Les molécules du complexe majeur d'histocompatibilité (CMH) sont au cœur de ce processus. Les CPA sont porteuses du CMH de classe II, qui inhibe la phagocitose. En d'autres termes, c'est « un ami présentant une identité ennemie ».
Inflammation
Chimiokines
Les chimiokines (parfois appelées, par anglicisme, chémokines[74]) sont une famille de petites protéines, majoritairement solubles. Les chimiokines sont des cytokines chimiotactiques qui contrôlent les motifs de migration et le positionnement des cellules immunitaires.
La sécrétion de ces chimiokines peut être induite lors de la réponse immune afin de favoriser l'arrivée de cellules du système immunitaire au niveau d'un site infectieux (notamment en activant l'intégrine des phagocytes).
Réorganisation du champ inflammatoire
L'inflammation est l'une des premières réponses globale du système immunitaire contre une infection ou une irritation. C'est un processus dit ubiquitaire ou universel qui concerne tous les tissus, faisant intervenir l'immunité innée et l'immunité adaptative. Elle est cependant inhibée dans le système immunitaire des muqueuses, dont le mécanisme d'action est spécifique.
L’activation de la réaction inflammatoire se fera grâce à des cytokines.
Au début d'une infection, d'une brûlure, ou d'une altération des tissus, la reconnaissance de motifs moléculaires associés aux pathogènes par les récepteurs de reconnaissance de motifs moléculaires exprimés par ces cellules conduit à leur activation et à la sécrétion de différents médiateurs, responsables des signes cliniques de l'inflammation (douleur, rougeur, chaleur et gonflement).
L'inflammation est déclenchée par l'action de médiateurs chimiques, qui déclenchent la phase vasculaire, ou vasculo-exsudative. Sous l'influence de médiateurs chimiques, les cellules endothéliales (formant les vaisseaux sanguins) s'activent. Cela entraîne une vasodilatation locale artériolaire puis capillaire qui provoque une augmentation de l'apport sanguin. L’augmentation de l'apport sanguin permettra d’évacuer les cellules mortes et les toxines (détersion), et d’apporter les éléments nécessaires à la guérison, notamment des globules blancs pour combattre les corps étrangers.
Une partie du liquide tissulaire exsudé sera également acheminée par les vaisseaux lymphatiques vers les ganglions lymphatiques régionaux. Une plus grande quantité de leucocytes, de débris cellulaires et de microbes passe dans la lymphe, pour lancer la phase de reconnaissance et d'attaque du système immunitaire adaptatif.
L'œdème a plusieurs fonctions : il permet l'apport jusqu'à la lésion de moyens de défense (immunoglobulines, protéines du complément...), la dilution de l'agent pathogène, et la limitation du foyer inflammatoire. Le mouvement du liquide plasmatique entraîne avec lui des protéines importantes, telles que la fibrine et les immunoglobulines (anticorps), dans le tissu enflammé. Comme pour les vaisseaux sanguins, les lymphatiques prolifèrent également dans les processus inflammatoires, pour répondre à la demande accrue.
L'inflammation permet d'établir une barrière efficace contre la dissémination d'éventuels agents infectieux, et ultérieurement, d'initier les processus de réparation tissulaire après l'élimination des agents pathogènes[réf. nécessaire].
Production des protéines de combat
En réponse à l'attaque, les cellules inflammatoires locales (granulocytes neutrophiles et macrophages) sécrètent diverses cytokines dans la circulation sanguine, en particulier des interleukines IL-1, IL-6 et IL-8, et le TNF-α. Ces cytokines activent la production par le foie de « protéine de phase aiguë ».
Ces protéines ont différentes fonctions qui seront exacerbées à l'occasion d'une inflammation : protéolyse, pour les protéases, coagulation du sang pour le fibrinogène, la prothrombine, protéines du système du complément, etc.
Les molécules
Système du complément
.png)
Le « système du complément » est un groupe d'environ 50 protéines connues du sérum, faisant partie de l'immunité innée. Douze (12) de ces protéines sont directement impliquées dans les mécanismes d'élimination des pathogènes, les autres régulent finement l'activité des premières afin d'éviter une réaction auto-immune (réaction contre le soi). Leur rôle initialement reconnu était de compléter l'action des immunoglobulines sériques, d'où leur nom.
L'activation du complément (éventuellement médiée par les anticorps) conduit au dépôt d'un complexe d'attaque membranaire à la surface des cellules infectées[75]. L'assemblage de ce complexe d'attaque membranaire créé des pores qui perturbent la membrane cellulaire des cellules cibles, entraînant la lyse et la mort des cellules pathogènes[76].
Dans cette activité qui mène à recouvrir les pathogènes et induire directement des perforations conduisant à la mort directe de l'organisme pathogène, les protéines du complément induisent également des activations variées :
- Induire le recrutement de cellules immunitaires, les lymphocytes B (initiant ainsi la réponse adaptative) ainsi que les macrophages phagocytant les pathogènes.
- Recouvrir certains agents pathogènes par opsonisation, permettant ainsi leur élimination par phagocytose.
- Métaboliser et éliminer les complexes immuns grâce aux récepteurs des fragments du complément.
- Stimuler l’inflammation.
- Activer du système immunitaire par les petits fragments de clivage proinflammatoires.
Les composants de la cascade du complément sont présents dans de nombreuses espèces en plus des mammifères, comme les plantes, les oiseaux, les poissons et quelques invertébrés[77].
Interféron
Les interférons (IFN) sont des protéines (glycoprotéines de la famille des cytokines). Chez la plupart des vertébrés, ils sont produits en réponse à la présence d'une double hélice d'ARN étranger dans l'organisme (plus généralement par la présence de structures moléculaires associées à des pathogènes[78]). L'interféron est secrété lorsque des quantités anormales de doubles hélices d'ARN sont détectées par le système immunitaire à l'intérieur de la cellule.
L'ARN double-brin étranger dans une cellule agit comme déclencheur de la production de l'interféron par cette cellule, et par les cellules voisines. La cellule originelle meurt, tuée par le virus à ARN ; par cytolyse virale. Elle libère des milliers de virus qui vont infecter les cellules voisines. Toutefois, ces cellules auront déjà commencé à produire ou recevoir des interférons, qui en quelque sorte « ont prévenu les cellules périphériques qu'il y avait un loup dans la bergerie ». Ces cellules ont en réaction déjà commencé à produire de grandes quantités d'une protéine dite « protéine-kinase R (en) » (ou PKR).
Si un virus infecte une cellule « pré-mise en garde » par l'interféron, la PKR est activé indirectement par l'ARN viral. Commence alors le transfert de groupements phosphate (phosphorylation) à une protéine dite eIF-2 (eIF-2 signifie « Eukaryotic Initiation Factor 2 » chez les eucaryotes). Après la phosphorylation, eIF2 a une capacité réduite de traduction de l'ARN et donc de production de protéines codées par l'ARN, ce qui freine ou empêche la réplication virale et inhibe la fonction des ribosomes dans la cellule, tuant les virus (et la cellule hôte si la réponse est activée assez longtemps). Tous les ARN au sein de la cellule sont également dégradés, ce qui freine l'infection, même si certains des eIF2 n'ont pas été phosphorylés.
Les interférons alpha et beta sont de type I. Ils génèrent un état antiviral par plusieurs mécanismes :
- résistance à la réplication (multiplication) virale intracellulaire ;
- augmentation de l'expression des MHC de classe I ;
- accroissement de la présentation de l'antigène ;
- activation des cellules NK pour éliminer les cellules infectées par le virus.
Notes et références
Références
- (en) Cet article est partiellement ou en totalité issu de l’article de Wikipédia en anglais intitulé « Innate immune system » (voir la liste des auteurs).
- ↑ (en) Paul Grasso, Essentials of Pathology for Toxicologists, CRC Press (lire en ligne)
- 1 2 (en) Bruce Alberts, Alexander Johnson, Julian Lewis, Martin Raff, Keith Roberts, and Peter Walters, Molecular Biology of the Cell; Fourth Edition, New York and London, Garland Science, (ISBN 0-8153-3218-1, lire en ligne)
- 1 2 (en) Hajime Kono et Kenneth L. Rock, « How dying cells alert the immune system to danger », Nature Reviews Immunology, vol. 8, no 4, , p. 279–289 (ISSN 1474-1741, PMID 18340345, PMCID PMC2763408, DOI 10.1038/nri2215, lire en ligne, consulté le )
- 1 2 (en) Elizabeth A. Grice et Julia A. Segre, « The skin microbiome », Nature Reviews Microbiology, vol. 9, no 4, , p. 244–253 (ISSN 1740-1526 et 1740-1534, PMID 21407241, PMCID PMC3535073, DOI 10.1038/nrmicro2537, lire en ligne, consulté le )
- ↑ IMMUNOLOGY - CHAPTER ONE > INNATE (NON-SPECIFIC) IMMUNITY Gene Mayer, Ph.D. Immunology Section of Microbiology and Immunology On-line. University of South Carolina
- 1 2 (en) S Ali et G Yosipovitch, « Skin pH: From Basic SciencE to Basic Skin Care », Acta Dermato Venereologica, vol. 93, no 3, , p. 261–267 (ISSN 0001-5555, DOI 10.2340/00015555-1531, lire en ligne, consulté le )
- ↑ (en) Joke A. Bouwstra, Gert S. Gooris, Frank E.R. Dubbelaar et Maria Ponec, « pH, Cholesterol Sulfate, and Fatty Acids Affect the Stratum Corneum Lipid Organization », Journal of Investigative Dermatology Symposium Proceedings, vol. 3, no 2, , p. 69–74 (DOI 10.1038/jidsymp.1998.17, lire en ligne, consulté le )
- 1 2 Marks J, Miller J. Lookingbill and Marks' Principles of Dermatology. 6th ed. Elsevier (2017).
- ↑ Josephine C. Moran, Jamal A. Alorabi et Malcolm J. Horsburgh, « Comparative Transcriptomics Reveals Discrete Survival Responses of S. aureus and S. epidermidis to Sapienic Acid », Frontiers in Microbiology, vol. 8, (ISSN 1664-302X, PMID 28179897, PMCID PMC5263133, DOI 10.3389/fmicb.2017.00033, lire en ligne, consulté le )
- ↑ Korting HC. Das Säuremantelkonzept von Marchionini und die Beeinflussung der Resident-Flora der Haut durch Waschungen in Abhängigkeit vom pH-Wert. In: Hautreinigung mit Syndets. Berlin: Springer (1990). p. 93–103.
- 1 2 3 4 5 (en) Elizabeth A. Grice, Heidi H. Kong, Sean Conlan et Clayton B. Deming, « Topographical and Temporal Diversity of the Human Skin Microbiome », Science, vol. 324, no 5931, , p. 1190–1192 (ISSN 0036-8075 et 1095-9203, PMID 19478181, PMCID PMC2805064, DOI 10.1126/science.1171700, lire en ligne, consulté le )
- ↑ (en) Stefanie Eyerich, Kilian Eyerich, Claudia Traidl-Hoffmann et Tilo Biedermann, « Cutaneous Barriers and Skin Immunity: Differentiating A Connected Network », Trends in Immunology, vol. 39, no 4, , p. 315–327 (DOI 10.1016/j.it.2018.02.004, lire en ligne, consulté le )
- ↑ (en) Joachim W. Fluhr, Jack Kao, Sung K. Ahn et Kenneth R. Feingold, « Generation of Free Fatty Acids from Phospholipids Regulates Stratum Corneum Acidification and Integrity », Journal of Investigative Dermatology, vol. 117, no 1, , p. 44–51 (DOI 10.1046/j.0022-202x.2001.01399.x, lire en ligne, consulté le )
- ↑ (en) Susan V. Lynch et Oluf Pedersen, « The Human Intestinal Microbiome in Health and Disease », New England Journal of Medicine, vol. 375, no 24, , p. 2369–2379 (ISSN 0028-4793 et 1533-4406, DOI 10.1056/NEJMra1600266, lire en ligne, consulté le )
- 1 2 (en) NIH Intramural Sequencing Center Comparative Sequencing Program, Keisha Findley, Julia Oh et Joy Yang, « Topographic diversity of fungal and bacterial communities in human skin », Nature, vol. 498, no 7454, , p. 367–370 (ISSN 0028-0836 et 1476-4687, PMID 23698366, PMCID PMC3711185, DOI 10.1038/nature12171, lire en ligne, consulté le )
- ↑ (en) Julia Oh, Allyson L. Byrd, Morgan Park et Heidi H. Kong, « Temporal Stability of the Human Skin Microbiome », Cell, vol. 165, no 4, , p. 854–866 (PMID 27153496, PMCID PMC4860256, DOI 10.1016/j.cell.2016.04.008, lire en ligne, consulté le )
- 1 2 (en) Shruti Naik, Nicolas Bouladoux, Jonathan L. Linehan et Seong-Ji Han, « Commensal–dendritic-cell interaction specifies a unique protective skin immune signature », Nature, vol. 520, no 7545, , p. 104–108 (ISSN 0028-0836 et 1476-4687, PMID 25539086, PMCID PMC4667810, DOI 10.1038/nature14052, lire en ligne, consulté le )
- ↑ (en) Yuping Lai, Anna Di Nardo, Teruaki Nakatsuji et Anke Leichtle, « Commensal bacteria regulate Toll-like receptor 3–dependent inflammation after skin injury », Nature Medicine, vol. 15, no 12, , p. 1377–1382 (ISSN 1078-8956 et 1546-170X, PMID 19966777, PMCID PMC2880863, DOI 10.1038/nm.2062, lire en ligne, consulté le )
- ↑ (en) Richard L. Gallo et Teruaki Nakatsuji, « Microbial Symbiosis with the Innate Immune Defense System of the Skin », Journal of Investigative Dermatology, vol. 131, no 10, , p. 1974–1980 (PMID 21697881, PMCID PMC3174284, DOI 10.1038/jid.2011.182, lire en ligne, consulté le )
- ↑ (en) Stephan R Krutzik, Belinda Tan, Huiying Li et Maria Teresa Ochoa, « TLR activation triggers the rapid differentiation of monocytes into macrophages and dendritic cells », Nature Medicine, vol. 11, no 6, , p. 653–660 (ISSN 1078-8956 et 1546-170X, PMID 15880118, PMCID PMC1409736, DOI 10.1038/nm1246, lire en ligne, consulté le )
- ↑ (en) Sean E. Doyle, Ryan M. O'Connell, Gustavo A. Miranda et Sagar A. Vaidya, « Toll-like Receptors Induce a Phagocytic Gene Program through p38 », The Journal of Experimental Medicine, vol. 199, no 1, , p. 81–90 (ISSN 1540-9538 et 0022-1007, PMID 14699082, PMCID PMC1887723, DOI 10.1084/jem.20031237, lire en ligne, consulté le )
- ↑ (en) Yuping Lai, Anna L. Cogen, Katherine A. Radek et Hyun Jeong Park, « Activation of TLR2 by a Small Molecule Produced by Staphylococcus epidermidis Increases Antimicrobial Defense against Bacterial Skin Infections », Journal of Investigative Dermatology, vol. 130, no 9, , p. 2211–2221 (PMID 20463690, PMCID PMC2922455, DOI 10.1038/jid.2010.123, lire en ligne, consulté le )
- ↑ (en) Dongqing Li, Hu Lei, Zhiheng Li et Hongquan Li, « A Novel Lipopeptide from Skin Commensal Activates TLR2/CD36-p38 MAPK Signaling to Increase Antibacterial Defense against Bacterial Infection », PLoS ONE, vol. 8, no 3, , e58288 (ISSN 1932-6203, PMID 23472173, PMCID PMC3589260, DOI 10.1371/journal.pone.0058288, lire en ligne, consulté le )
- ↑ (en) Ines Wanke, Heiko Steffen, Christina Christ et Bernhard Krismer, « Skin Commensals Amplify the Innate Immune Response to Pathogens by Activation of Distinct Signaling Pathways », Journal of Investigative Dermatology, vol. 131, no 2, , p. 382–390 (DOI 10.1038/jid.2010.328, lire en ligne, consulté le )
- ↑ « Antimicrobial peptides: premises and promises », International Journal of Antimicrobial Agents, vol. 24, no 6, , p. 536–47 (PMID 15555874, DOI 10.1016/j.ijantimicag.2004.09.005)
- ↑ (en) Katherine Radek et Richard Gallo, « Antimicrobial peptides: natural effectors of the innate immune system », Seminars in Immunopathology, vol. 29, no 1, , p. 27–43 (ISSN 1863-2297 et 1863-2300, DOI 10.1007/s00281-007-0064-5, lire en ligne, consulté le )
- ↑ (en) Dan Hultmark, Håkan Steiner, Torgny Rasmuson et Hans G. Boman, « Insect Immunity. Purification and Properties of Three Inducible Bactericidal Proteins from Hemolymph of Immunized Pupae of Hyalophora cecropia », European Journal of Biochemistry, vol. 106, no 1, , p. 7–16 (DOI 10.1111/j.1432-1033.1980.tb05991.x, lire en ligne, consulté le )
- ↑ (en) Bals R et Wang X, « Mouse Beta-Defensin 3 Is an Inducible Antimicrobial Peptide Expressed in the Epithelia of Multiple Organs », sur Infection and immunity, 1999 jul (PMID 10377137, consulté le )
- ↑ « Control of cell selectivity of antimicrobial peptides », Biochimica et Biophysica Acta, vol. 1788, no 8, , p. 1687–92 (PMID 18952049, DOI 10.1016/j.bbamem.2008.09.013)
- ↑ Seong SY, Matzinger P, « Hydrophobicity: an ancient damage-associated molecular pattern that initiates innate immune responses », Nature Reviews. Immunology, vol. 4, no 6, , p. 469–78 (PMID 15173835, DOI 10.1038/nri1372)
- ↑ Panayi GS, Corrigall VM, Henderson B, « Stress cytokines: pivotal proteins in immune regulatory networks; Opinion », Current Opinion in Immunology, vol. 16, no 4, , p. 531–4 (PMID 15245751, DOI 10.1016/j.coi.2004.05.017)
- ↑ Scaffidi P, Misteli T, Bianchi ME, « Release of chromatin protein HMGB1 by necrotic cells triggers inflammation », Nature, vol. 418, no 6894, , p. 191–5 (PMID 12110890, DOI 10.1038/nature00858)
- ↑ Scheibner KA, Lutz MA, Boodoo S, Fenton MJ, Powell JD, Horton MR, « Hyaluronan fragments act as an endogenous danger signal by engaging TLR2 », Journal of Immunology, vol. 177, no 2, , p. 1272–81 (PMID 16818787, DOI 10.4049/jimmunol.177.2.1272)
- ↑ Boeynaems JM, Communi D, « Modulation of inflammation by extracellular nucleotides », The Journal of Investigative Dermatology, vol. 126, no 5, , p. 943–4 (PMID 16619009, DOI 10.1038/sj.jid.5700233)
- ↑ Bours MJ, Swennen EL, Di Virgilio F, Cronstein BN, Dagnelie PC, « Adenosine 5'-triphosphate and adenosine as endogenous signaling molecules in immunity and inflammation », Pharmacology & Therapeutics, vol. 112, no 2, , p. 358–404 (PMID 16784779, DOI 10.1016/j.pharmthera.2005.04.013)
- ↑ Shi Y, Evans JE, Rock KL, « Molecular identification of a danger signal that alerts the immune system to dying cells », Nature, vol. 425, no 6957, , p. 516–21 (PMID 14520412, DOI 10.1038/nature01991, Bibcode 2003Natur.425..516S)
- 1 2 Farkas AM, Kilgore TM, Lotze MT, « Detecting DNA: getting and begetting cancer », Current Opinion in Investigational Drugs, vol. 8, no 12, , p. 981–6 (PMID 18058568)
- ↑ Rubartelli A, Lotze MT, « Inside, outside, upside down: damage-associated molecular-pattern molecules (DAMPs) and redox », Trends in Immunology, vol. 28, no 10, , p. 429–36 (PMID 17845865, DOI 10.1016/j.it.2007.08.004)
- 1 2 (en) Charles Janeway, Paul Travers, Mark Walport, and Mark Shlomchik, Immunobiology, New York et London, Garland Science, , 5e éd. (ISBN 0-8153-4101-6, lire en ligne).
- ↑ (en) Mooney JP, « Malaria, Anemia, and Invasive Bacterial Disease: A Neutrophil Problem? », J Leukoc Biol, vol. 2019, no 165, , p. 645–55 (DOI 10.1002/JLB.3RI1018-400R)
- ↑ (en) Adelheid Cerwenka et Lewis L. Lanier, « Natural killer cells, viruses and cancer », Nature Reviews Immunology, vol. 1, no 1, , p. 41–49 (ISSN 1474-1733 et 1474-1741, DOI 10.1038/35095564, lire en ligne, consulté le )
- ↑ (en) Eric Vivier, David H. Raulet, Alessandro Moretta et Michael A. Caligiuri, « Innate or Adaptive Immunity? The Example of Natural Killer Cells », Science, vol. 331, no 6013, , p. 44–49 (ISSN 0036-8075 et 1095-9203, PMID 21212348, PMCID PMC3089969, DOI 10.1126/science.1198687, lire en ligne, consulté le )
- ↑ (en) Ingeborg Becker, Norma Salaiza, Magdalena Aguirre et José Delgado, « Leishmania lipophosphoglycan (LPG) activates NK cells through toll-like receptor-2 », Molecular and Biochemical Parasitology, vol. 130, no 2, , p. 65–74 (DOI 10.1016/S0166-6851(03)00160-9, lire en ligne, consulté le )
- ↑ Hart OM, Athie-Morales V, O’Connor GM, Gardiner CM. TLR7/8-mediated activation of human NK cells results in accessory cell-dependent IFN-gamma production. J Immunol (2005) 175(3):1636–42.
- ↑ (en) Mariella Della Chiesa, Chiara Romagnani, Andreas Thiel et Lorenzo Moretta, « Multidirectional interactions are bridging human NK cells with plasmacytoid and monocyte-derived dendritic cells during innate immune responses », Blood, vol. 108, no 12, , p. 3851–3858 (ISSN 0006-4971 et 1528-0020, DOI 10.1182/blood-2006-02-004028, lire en ligne, consulté le )
- ↑ (en) Klas Kärre, « Natural killer cell recognition of missing self », Nature Immunology, vol. 9, no 5, , p. 477–480 (ISSN 1529-2908 et 1529-2916, DOI 10.1038/ni0508-477, lire en ligne, consulté le )
- ↑ (en) Ofer Mandelboim, Niva Lieberman, Marianna Lev et Lada Paul, « Recognition of haemagglutinins on virus-infected cells by NKp46 activates lysis by human NK cells », Nature, vol. 409, no 6823, , p. 1055–1060 (ISSN 0028-0836 et 1476-4687, DOI 10.1038/35059110, lire en ligne, consulté le )
- ↑ (en) Georg Gasteiger, Xiying Fan, Stanislav Dikiy et Sue Y. Lee, « Tissue residency of innate lymphoid cells in lymphoid and nonlymphoid organs », Science, vol. 350, no 6263, , p. 981–985 (ISSN 0036-8075 et 1095-9203, PMID 26472762, PMCID PMC4720139, DOI 10.1126/science.aac9593, lire en ligne, consulté le )
- ↑ (en) Orr-El Weizman, Eric Song, Nicholas M. Adams et Andrew D. Hildreth, « Mouse cytomegalovirus-experienced ILC1s acquire a memory response dependent on the viral glycoprotein m12 », Nature Immunology, vol. 20, no 8, , p. 1004–1011 (ISSN 1529-2908 et 1529-2916, PMID 31263280, PMCID PMC6697419, DOI 10.1038/s41590-019-0430-1, lire en ligne, consulté le )
- ↑ (en) Shinichi Okuzumi, Jun Miyata, Hiroki Kabata et Takao Mochimaru, « TLR7 Agonist Suppresses Group 2 Innate Lymphoid Cell–mediated Inflammation via IL-27–Producing Interstitial Macrophages », American Journal of Respiratory Cell and Molecular Biology, vol. 65, no 3, , p. 309–318 (ISSN 1044-1549 et 1535-4989, DOI 10.1165/rcmb.2021-0042OC, lire en ligne, consulté le )
- ↑ (en) Antony N. Antoniou et Simon J. Powis, « Pathogen evasion strategies for the major histocompatibility complex class I assembly pathway », Immunology, vol. 124, no 1, , p. 1–12 (ISSN 0019-2805 et 1365-2567, PMID 18284468, PMCID PMC2434379, DOI 10.1111/j.1365-2567.2008.02804.x, lire en ligne, consulté le )
- ↑ Bhat R, Watzl C. Serial killing of tumor cells by human natural killer cells – enhancement by therapeutic antibodies. PLoS One (2007) 2:e326. doi:10.1371/journal.pone.0000326
- ↑ Smyth MJ, Cretney E, Kelly JM, Westwood JA, Street SE, Yagita H, et al. Activation of NK cell cytotoxicity. Mol Immunol (2005) 42:501–10. doi:10.1016/j.molimm.2004.07.034
- ↑ (en) Maria Eugenia Guicciardi et Gregory J. Gores, « Life and death by death receptors », The FASEB Journal, vol. 23, no 6, , p. 1625–1637 (ISSN 0892-6638 et 1530-6860, PMID 19141537, PMCID PMC2698650, DOI 10.1096/fj.08-111005, lire en ligne, consulté le )
- ↑ A. Ashkenazi, « Death Receptors: Signaling and Modulation », Science, vol. 281, no 5381, , p. 1305–1308 (DOI 10.1126/science.281.5381.1305, lire en ligne, consulté le )
- ↑ (en) Craig T. Morita, Chenggang Jin, Ghanashyam Sarikonda et Hong Wang, « Nonpeptide antigens, presentation mechanisms, and immunological memory of human Vγ2Vδ2 T cells: discriminating friend from foe through the recognition of prenyl pyrophosphate antigens », Immunological Reviews, vol. 215, no 1, , p. 59–76 (ISSN 0105-2896 et 1600-065X, DOI 10.1111/j.1600-065X.2006.00479.x, lire en ligne, consulté le )
- ↑ (en) Casey T. Weaver, Laurie E. Harrington, Paul R. Mangan et Maya Gavrieli, « Th17: An Effector CD4 T Cell Lineage with Regulatory T Cell Ties », Immunity, vol. 24, no 6, , p. 677–688 (DOI 10.1016/j.immuni.2006.06.002, lire en ligne, consulté le )
- ↑ (en) Estelle Bettelli, Thomas Korn, Mohamed Oukka et Vijay K. Kuchroo, « Induction and effector functions of TH17 cells », Nature, vol. 453, no 7198, , p. 1051–1057 (ISSN 0028-0836 et 1476-4687, PMID 18563156, PMCID PMC6280661, DOI 10.1038/nature07036, lire en ligne, consulté le )
- ↑ (en) Heon Park, Zhaoxia Li, Xuexian O Yang et Seon Hee Chang, « A distinct lineage of CD4 T cells regulates tissue inflammation by producing interleukin 17 », Nature Immunology, vol. 6, no 11, , p. 1133–1141 (ISSN 1529-2908 et 1529-2916, PMID 16200068, PMCID PMC1618871, DOI 10.1038/ni1261, lire en ligne, consulté le )
- ↑ (en) Elisabetta Volpe, Nicolas Servant, Raphaël Zollinger et Sofia I Bogiatzi, « A critical function for transforming growth factor-β, interleukin 23 and proinflammatory cytokines in driving and modulating human TH-17 responses », Nature Immunology, vol. 9, no 6, , p. 650–657 (ISSN 1529-2908 et 1529-2916, DOI 10.1038/ni.1613, lire en ligne, consulté le )
- ↑ (en) Daniel J. Cua et Cristina M. Tato, « Innate IL-17-producing cells: the sentinels of the immune system », Nature Reviews Immunology, vol. 10, no 7, , p. 479–489 (ISSN 1474-1733 et 1474-1741, DOI 10.1038/nri2800, lire en ligne, consulté le )
- ↑ (en) Dario A. A. Vignali, Lauren W. Collison et Creg J. Workman, « How regulatory T cells work », Nature Reviews Immunology, vol. 8, no 7, , p. 523–532 (ISSN 1474-1733 et 1474-1741, PMID 18566595, PMCID PMC2665249, DOI 10.1038/nri2343, lire en ligne, consulté le )
- ↑ (en) R-F Wang, Y Miyahara et H Y Wang, « Toll-like receptors and immune regulation: implications for cancer therapy », Oncogene, vol. 27, no 2, , p. 181–189 (ISSN 0950-9232 et 1476-5594, DOI 10.1038/sj.onc.1210906, lire en ligne, consulté le )
- ↑ (en) Mindi R.Walker, Deborah J. Kasprowicz, Vivian H. Gersuk et Angéle Bènard, « Induction of FoxP3 and acquisition of T regulatory activity by stimulated human CD4+CD25– T cells », Journal of Clinical Investigation, vol. 112, no 9, , p. 1437–1443 (ISSN 0021-9738, DOI 10.1172/JCI200319441, lire en ligne, consulté le )
- ↑ (en) Roli Khattri, Tom Cox, Sue-Ann Yasayko et Fred Ramsdell, « An essential role for Scurfin in CD4+CD25+ T regulatory cells », Nature Immunology, vol. 4, no 4, , p. 337–342 (ISSN 1529-2908 et 1529-2916, DOI 10.1038/ni909, lire en ligne, consulté le )
- ↑ (en) Shohei Hori, Takashi Nomura et Shimon Sakaguchi, « Control of Regulatory T Cell Development by the Transcription Factor Foxp3 », Science, vol. 299, no 5609, , p. 1057–1061 (ISSN 0036-8075 et 1095-9203, DOI 10.1126/science.1079490, lire en ligne, consulté le )
- ↑ (en) Jason D. Fontenot, Marc A. Gavin et Alexander Y. Rudensky, « Foxp3 programs the development and function of CD4+CD25+ regulatory T cells », Nature Immunology, vol. 4, no 4, , p. 330–336 (ISSN 1529-2908 et 1529-2916, DOI 10.1038/ni904, lire en ligne, consulté le )
- ↑ (en) Shin Li Chia, Simran Kapoor, Cyril Carvalho et Marc Bajénoff, « Mast cell ontogeny: From fetal development to life‐long health and disease », Immunological Reviews, vol. 315, no 1, , p. 31–53 (ISSN 0105-2896 et 1600-065X, DOI 10.1111/imr.13191, lire en ligne, consulté le )
- ↑ (en) Francesca Levi-Schaffer, Bernhard F. Gibbs, Jenny Hallgren et Carlo Pucillo, « Selected recent advances in understanding the role of human mast cells in health and disease », Journal of Allergy and Clinical Immunology, vol. 149, no 6, , p. 1833–1844 (DOI 10.1016/j.jaci.2022.01.030, lire en ligne, consulté le )
- ↑ (en) Ulrich Blank, Hua Huang et Toshiaki Kawakami, « The high affinity IgE receptor: a signaling update », Current Opinion in Immunology, vol. 72, , p. 51–58 (DOI 10.1016/j.coi.2021.03.015, lire en ligne, consulté le )
- ↑ (en) Frank A. Redegeld, Yingxin Yu, Sangeeta Kumari et Nicolas Charles, « Non‐IgE mediated mast cell activation », Immunological Reviews, vol. 282, no 1, , p. 87–113 (ISSN 0105-2896 et 1600-065X, DOI 10.1111/imr.12629, lire en ligne, consulté le )
- ↑ (en) Saptarshi Roy, Chalatip Chompunud Na Ayudhya, Monica Thapaliya et Vishwa Deepak, « Multifaceted MRGPRX2: New insight into the role of mast cells in health and disease », Journal of Allergy and Clinical Immunology, vol. 148, no 2, , p. 293–308 (PMID 33957166, PMCID PMC8355064, DOI 10.1016/j.jaci.2021.03.049, lire en ligne, consulté le )
- ↑ Kenneth Murphy et Pierre L. Masson (trad. de l'anglais), Immunobiologie de Janeway, Louvain-la-Neuve (Belgique)/Paris/impr. en Italie, De Boeck supérieur, dl 2018, 885 p. (ISBN 978-2-8073-0612-7 et 2-8073-0612-8, OCLC 1032296493, lire en ligne)
- ↑ Dictionnaire de l’Académie de médecine, “Chémokine”. http://dictionnaire.academie-medecine.fr/?q=ch%C3%A9mokine
- ↑ Xie CB, Jane-Wit D, Pober JS, « Complement Membrane Attack Complex: New Roles, Mechanisms of Action, and Therapeutic Targets », The American Journal of Pathology, vol. 190, no 6, , p. 1138–1150 (PMID 32194049, PMCID 7280757, DOI 10.1016/j.ajpath.2020.02.006)
- ↑ CA Jr Janeway, Travers P, Walport M et al., « The complement system and innate immunity », sur Immunobiology: The Immune System in Health and Disease, New York, Garland Science, (consulté le )
- ↑ (en) Janeway CA, Jr. et al., Immunobiology., Garland Science, , 6e éd. (ISBN 0-443-07310-4)
- ↑ George D Kalliolias et Lionel B Ivashkiv, « Overview of the biology of type I interferons », Arthritis Research & Therapy, vol. 12, no Suppl 1, , S1 (ISSN 1478-6354, PMID 20392288, PMCID 2991774, DOI 10.1186/ar2881, lire en ligne, consulté le )
Articles connexes
- Immunité passive
- Système immunitaire
- Système immunitaire adaptatif
- Récepteur de reconnaissance de motifs moléculaires.
- Motif moléculaire associé aux pathogènes
- Chimiokines
- Peptide antimicrobien
- Protéine de phase aiguë
- système du complément
- Motif moléculaire associé aux dégâts
- Complexe d'attaque membranaire
- Portail de la biologie
- Portail de la médecine